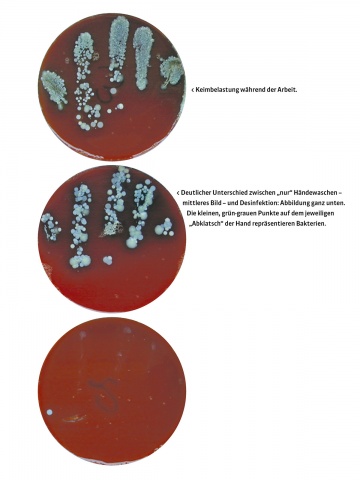

Erreger im Keim ersticken
Keime – Mit freiem Auge unsichtbar, existieren sie ganz natürlich auf unserem Körper und vor allem auf unseren Händen. Im Alltag werden sie deshalb nur allzu gerne vergessen oder gar nicht erst bewusst wahrgenommen. Für gesunde Menschen ist das auch nicht weiter problematisch, denn für sie ist das meist harmlos. Im Kontakt mit kranken und geschwächten Personen allerdings können Keime auf den Händen für zusätzliche Herausforderung sorgen und unter Umständen Komplikationen verursachen. Fachgerechte Hygiene kann diese buchstäblich bereits im Keim ersticken und ist daher vor allem in Krankenhäusern ein Muss – und zwar in allen Abteilungen, quer über alle Berufsgruppen hinweg, ohne Ausnahme.
Um diese Tatsache einmal mehr deutlich zu machen, holt das Hygieneteam der Vorarlberger Landeskrankenhäuser den Stellenwert der fachgerechten Händehygiene mit einer interaktiven Wanderausstellung vor den Vorhang. Spannende und anschauliche Zugänge zu diesem Thema sind seit Anfang Mai 2024 zunächst im Foyer des LKH Rankweil zu sehen. Start war anlässlich des Internationalen Tages der Händehygiene, der jährlich am 5. Mai stattfindet. In den darauffolgenden Monaten wird die Ausstellung dann nach und nach durch alle Häuser der VLKH wandern, um dort jeweils mehrere Wochen Station zu machen.
Auf bis zu zehn Schautafeln machen die Hygiene-Experten nun interaktiv sichtbar, was unserem Auge sonst verborgen bleibt: „Wir präsentieren faszinierende mikroskopische Ansichten und ausgezeichnete Plakat- und Video-Arbeiten zum Thema Händehygiene, die von Studenten und Studentinnen der Vorarlberger Pflegeschule und der Fachhochschule Vorarlberg umgesetzt wurden. All dem stellen wir spannende Experimentierstationen zur Seite“, kündigt Miriam Kalcher an, sie ist Hygienefachkraft am Landeskrankenhaus Hohenems. „Dieser Mix erlaubt einen Einblick in die Welt der Krankenhaushygiene, der für Krankenhaus-Mitarbeiter, Patienten und Bevölkerung gleichermaßen interessant ist.“ Mit dabei ist etwa die bewährte „Didaktobox“, ein Instrument, mit der der Erfolg der eigenen Händedesinfektion sichtbar gemacht werden kann: Durch Beimischung eines fluoreszierenden Farbstoffes erkennt das Gerät über UV-Lampen, wie effizient die Verteilung des Desinfektionsmittels auf den Händen war. „Die Ergebnisse sind auch für langgediente Mitarbeiter immer wieder aufs Neue erstaunlich.“
„Selbstverständlich, wie im Schlaf“
Generell spielt der Schutz von Mitarbeitern und Patienten im Krankenhaus eine grundlegende Rolle: Letztere sind meist durch eine Erkrankung in ihrer Immunabwehr geschwächt. Im alltäglichen klinischen Umfeld haben Erkennung und Verhütung von möglichen Infektionen daher höchste Priorität. Konsequente Hygienemaßnahmen zählen zu den wichtigsten Schutzpfeilern. Und dabei kommt der Händehygiene noch einmal eine ganz besondere Bedeutung zu – in den Krankenhäusern insbesonders die hygienische-, aber auch die chirurgische Händedesinfektion. Die Weltgesundheitsorganisation WHO bezeichnet die Händehygiene sogar als die „wichtigste Einzelmaßnahme zur Infektionsvermeidung“ und erinnert jedes Jahr am 5. Mai mit dem Internationalen Tag der Händehygiene daran.
In den Vorarlberger Landeskrankenhäusern ist dieser Tag seit Jahren jeweils Auftakt für besondere Händehygiene-Aktionen. Das Team der Krankenhaushygiene macht die Mitarbeiterschaft speziell auf die Bedeutung der richtigen Händedesinfektion aufmerksam, nützt diesen Welttag als Basis für Bewusstseinsbildung in allen Landeskrankenhäusern. Abseits davon finden über das gesamte Jahr hinweg diverse Schulungen und Hygienevisiten auf den einzelnen Abteilungen statt. „Je öfter man davon hört, desto selbstverständlicher wird das Thema und desto fester verankert bleibt es auch im Alltag. Das haben wir in den vergangenen Jahren sehr positiv erfahren: Händedesinfektion ganz selbstverständlich, automatisch, quasi wie im Schlaf – das ist der Idealfall“, zieht das Hygieneteam Zwischenbilanz.
30 Sekunden, die Leben retten können
Wesentlich für den Erfolg der Händedesinfektion ist die richtige Anwendung: Das Desinfektionsmittel muss für mindestens eine halbe Minute auf den Händen verrieben werden. „Die gesamte Oberfläche muss benetzt werden, um krankmachende Keime unschädlich machen zu können“, erklärt Karin Pohl, Hygienefachkraft am Landeskrankenhaus Rankweil. Die richtige Technik zu schulen und zu üben ist ein wichtiger Teil der Hygienearbeit. Und die Expertin betont: „Wir können es gar nicht oft genug wiederholen. Denn auch im ärgsten Alltagsstress ist die Einhaltung dieser 30 Sekunden für die Händedesinfektion einfach enorm wichtig. Im Fall der Fälle sogar lebenswichtig.“
Eine grundlegende Voraussetzung, um eine korrekte Händedesinfektion bei hygienerelevanten Tätigkeiten im Krankenhaus durchführen zu können ist, dass die Hände frei von Schmuck wie Armbanduhren, Armbändern, Freundschaftsbändern und Ringen sind. „Auch Eheringe sind da leider nicht ausgenommen“, erklärt Bianca Zauner, Hygienefachkraft am Landeskrankenhaus Bludenz. Nagellack und künstliche Fingernägel sind ebenfalls ungeeignet. Eine eigens gestaltete Plakatserie zu diesem Thema wird heuer zusätzlich und das gesamte Jahr über in allen Häusern der VLKH über diesen besonderen Aspekt der Händehygiene aufmerksam machen.
All diese stetigen Bemühungen des Hygieneteams wieder einmal ins Bewusstsein zu rufen und auch die Bevölkerung auf diesen Aspekt der Patientensicherheit aufmerksam zu machen, ist also das erklärte Ziel der neuen Wanderausstellung und der damit verbundenen Aktionen: „Es ist ein Thema, das man nicht auf den ersten Blick sieht, auf den zweiten aber sehr wohl! Es ist uns daher wichtig, zu zeigen, dass wir alles dafür tun, dass Hygiene in den Vorarlberger Landeskrankenhäusern funktioniert.“
Krankenhaushygiene in den VLKH
Seit 15 Jahren gibt es das „Institut für Krankenhaushygiene und Infektionsvorsorge“ mit Hauptsitz im Schwerpunktkrankenhaus Feldkirch in seiner heutigen Form.
Das Fachteam besteht derzeit aus acht Hygienefachkräften und zwei Ärzten.
Zu den Aufgaben des Teams zählen vor allem das Erkennen, Überwachen, Verhüten und Bekämpfen von Infektionen.
Die Hygiene-Experten arbeiten standortübergreifend zusammen und sind in allen Häusern des Spitalsverbundes vertreten.













Kommentare